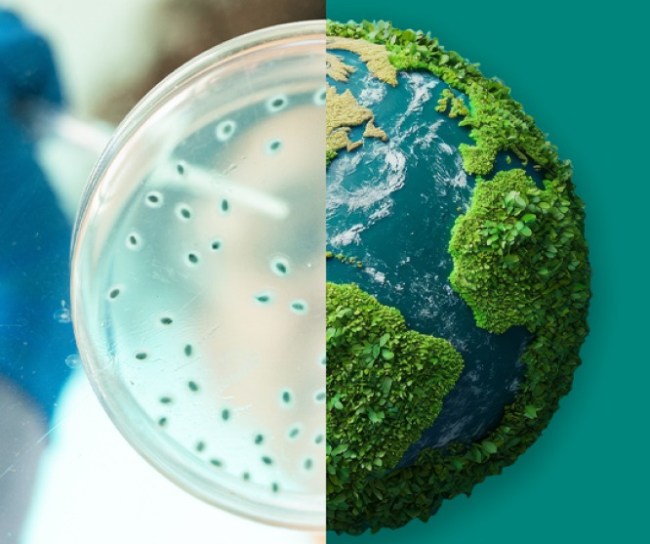
Image showing microbes in a lab dish on the left and earth on the right

Investor relations
Our science-led strategy is key to delivering long-term value for patients, employees and shareholders.
NYSE: MRK
July 3, 2026 9:10 am ET
Delayed at least 20 minutes
Latest news, events & financials
June 09, 2026
June 04, 2026
June 01, 2026
May 26, 2026
April 30, 2026
March 25, 2026
March 03, 2026
February 03, 2026
January 12, 2026
Q2 2026 Earnings Call
August 4, 2026
Dial: (800) 369-3351 (U.S. and Canada Toll-Free) or (517) 308-9448 (International)
Access Code: 9818590
Our pipeline shows our relentless pursuit of the next breakthrough.

Our leadership
Our deep bench of talent has the knowledge, commitment and expertise to successfully execute on our innovation strategy.
Sustainability
Supporting the future of our business and the health and well-being of patients, people and communities around the world.

 1Q26 Merck Earnings Presentation
1Q26 Merck Earnings Presentation






